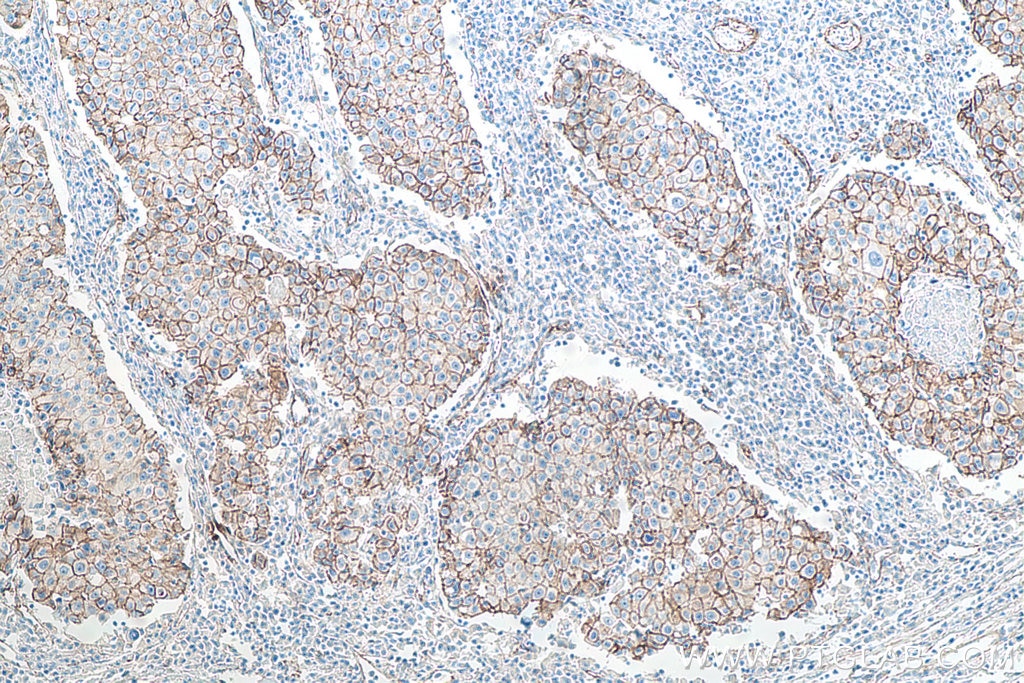

IHCeasy p120 Catenin Ready-To-...
- Article
- IHCeasy p120 Catenin Ready-To-Use IHC Kit
- Product Number
- KHC0009-50T
- Supplier
- Proteintech
- Size
- 50 tests
- Description
- KHC0009 is a ready-to-use IHC kit for staining of p120 Catenin. The kit provides all reagents, from antigen retrieval to cover slip mounting, that require little to no diluting or handling prior to use. Simply apply the reagents to your sample slide according to the protocol and you're steps away from obtaining high-quality IHC data.
- Category
- Lab Reagents & Chemicals
- Product Group
- Biochemicals
- Application
- IHC
- Host
- Goat, Mouse
- Species reactivity
- Human, Mouse, Rat
- Conjugate
- Horseradish Peroxidase
- Formulation
- Tris-base 0.5M, EDTA-2Na 0.05M
- Supplier URL
- Visit supplier product page